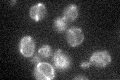
YGL143C
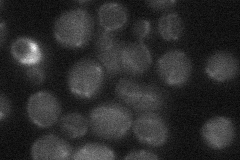
YGL143C
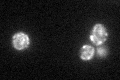
YGL143C
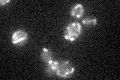
YGL143C

View description
Mitochondrial translation release factor, involved in stop codon recognition and hydrolysis of the peptidyl-tRNA bond during mitochondrial translation; lack of MRF1 causes mitochondrial genome instability
Localization:
Intensity:
Fold change:
Significance:
-
C’ GFP library in SD
mitochondria25.49 -
N' NOP1pr-GFP in SD

mitochondria59.9208 -
N' TEF2pr-mCherry in SD

mitochondria0 -
N' NATIVEpr-GFP in SD
mitochondria21.6943 -
N' TEF2pr-VC and Cyto-VN in SD

#N/A0 -
C’ GFP library in SD+DTT
mitochondria25.81.01No -
C’ GFP library in SD+H2O2

mitochondria26.71.04No -
C’ GFP library in Starvation Media
mitochondria20.190.79No -
C’ GFP library on the background of Pup2-DaMP

mitochondria -
C’ GFP library on the background of CCT mutant

mitochondria26.51621.03978No
